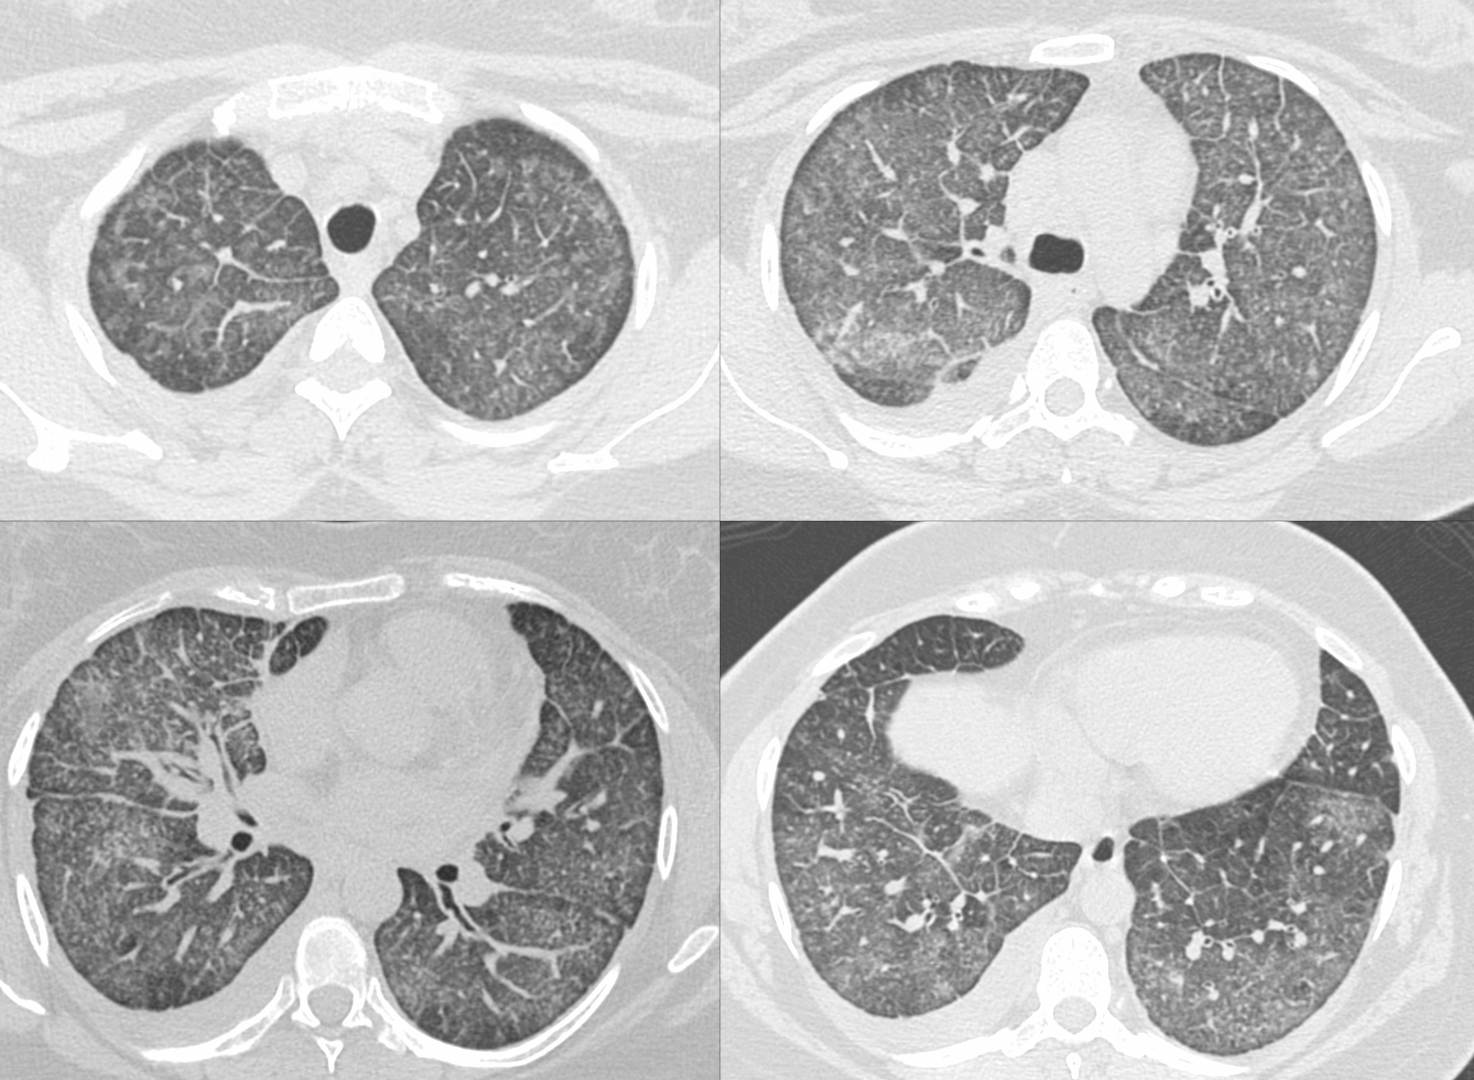

Case 115 - Ground Glass + Septal Thickening
Ground glass plus septal thickening has a specific set of conditions that can be differentiated based on appearance morphology, presentation (acute/subacute/chronic) and presence of other findings in the chest or elsewhere on whole body scanning
New One-Time, Lifetime Subscription
Please check out this page to see the changes in subscription models.

Current Post
This 36-years old presented with gradually progressive breathlessness
What is the diagnosis?

The video describes an approach to a case like this using this flow chart.
This post is for subscribers only
SubscribeAlready have an account? Log in
